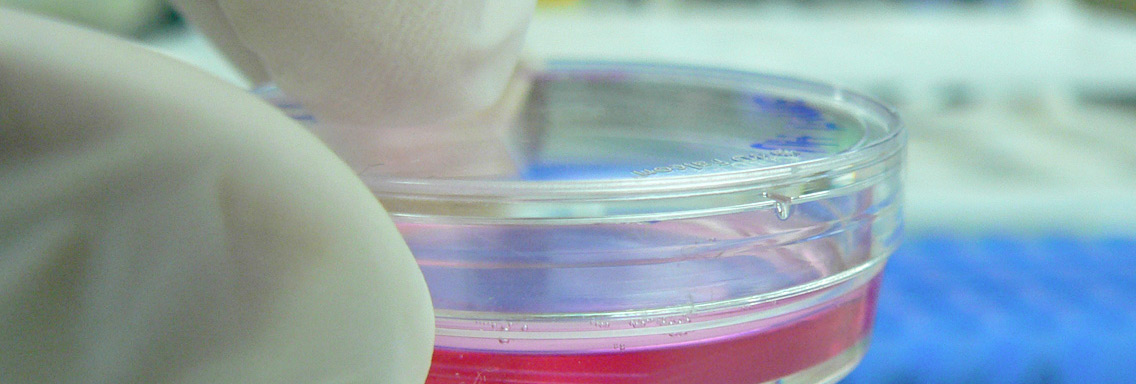
A close up of a petri dish

Find collaborative research expertise
Life Sciences Institute
UBC’s world class expertise in Life Sciences, cutting edge equipment, strong clinical integration, flexible IP policies and low overhead create an attractive value proposition and foster numerous industrial collaborations. LSI researchers are working with both local and global industrial partners and over 80 of the Institute's technologies have been successfully commercialized. LSI researchers have founded over 20 companies with diverse products and technologies in cancer and viral infection care, environmental drug discovery, and immunotherapy for treatment of several prevalent, chronic diseases including IBD and diabetes.
Centre for Tuberculosis Research
Regroups scientists from UBC, Vancouver General Hospital and the BC Centre for Disease Control to understand how drug resistant strains of Mycobacterium tuberculosis infects and establishes itself in humans — key to the development of effective new drugs against the bacterium.
Proteomics and Metabolomics Core Facility
The Proteomics Core Facility (PCF) has been providing mass spectrometry and proteomic services to Lower Mainland research labs including universities, non-profit organizations, hospitals, and biotechnology corporations for over a decade. Specializing in characterizing post translational modifications and quantitative proteomics, the facility can provide comprehensive analysis for a broad range of proteomics projects using the latest techniques.
Biostatistical Research Group
Provides a focal point for faculty and graduate students who develop and disseminate methods for data analysis in the health and life sciences. Activities include methodological research, collaborative research, consultation, and support and service to the broader biostatistical community. The group co-operates with related agencies and efforts: clinical trials and health promotion centres, the BC Ministry of Health, the BC Cancer Agency and other clinical research organizations and the Canadian Society for Epidemiology and Biostatistics.
ubcFLOW
The cytometry facility was established over twenty years ago and has been growing each year. From a single cell sorter and cell analyser and have expanded to six high end cell sorters and seven analysers, all equipped with multiple laser and detectors to accommodate the variety of work performed at UBC. The facility supports the research needs of the UBC and wider community by providing a very flexible sorting service to accommodate the diverse needs.
Sequencing Facililty
The School of Biomedical Engineering (SBME) Sequencing Core (formerly BRC-Seq) is dedicated to providing Single-Cell and Next-Generation Sequencing Services and training to the Research Community. We work collaboratively with the Michael Smith Genome Sciences Center and the Michael Smith Laboratories, and are located at the Biomedical Research Center at UBC.
Related spin off companies
- Andira Medical
- Alpha-9 Oncology
- Safecoat Medical
- Palamedrix
- Abcellera
- Anandia Labs
- Aspect Biosystems
- Metamixis
- Microbiome Insights
- Anandia Labs
- Vedanta
- 3Ci
- KMH Pharmaceuticals
- Curatio
- ContextualGenomics
- EnGene
- TerraGen Discovery
- Tekmira
- QLT
- Prescient NeuroPharma Inc. (Formerly IGT Pharma)
- Aurora Biomed
- Immune Network
- Biomarin Pharmaceutical Inc. (Formerly Synapse Technologies)
- Migenix (Formerly Micrologix Biotech)
- NeuroMed Technologies
- NeuroVir Therapeutics (Acquired by MediGene)
- Point Grey Research
- Raven Biotech
- TapImmune (Formerly GeneMax Pharmaceuticals)
- Inimex Pharmaceuticals
- Network Immunology (Formerly Hoffmann Technologies)
- Aquinox Pharmaceuticals
- Boreal Genomics
- Zymeworks
- BioAMPS International
- Precision Nanosystems
- bioMmune Technologies
- Commense
- Delic Labs